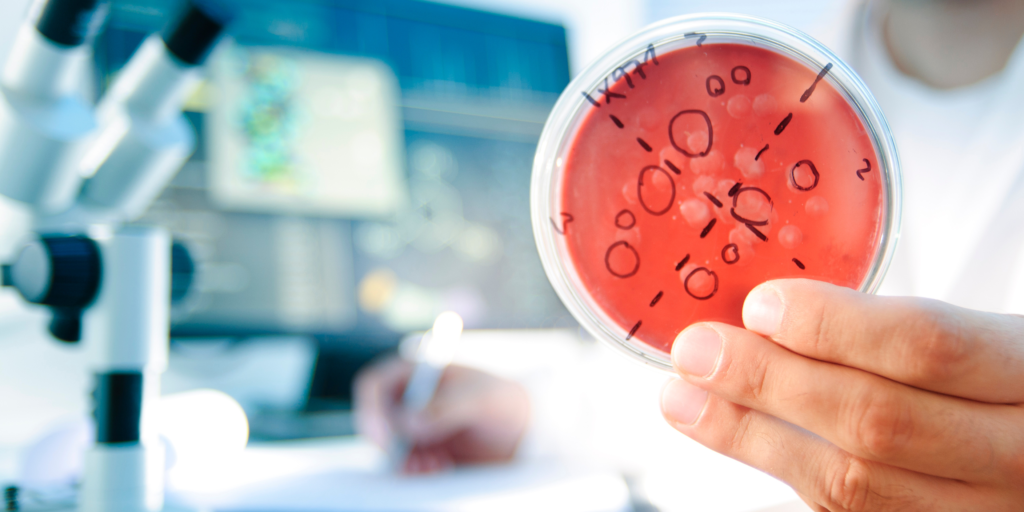

Por que o Teste de Bioburden é Essencial?
O teste de Bioburden é a determinação da presença de microorganismos viáveis em uma amostra. Geralmente o ensaio é realizado com a finalidade de “alertar precoce” de possíveis problemas que podem ser encontrados no produto acabado.
Usualmente determina-se essa carga microbiana ao longo do processo produtivo, afim de obter um controle de qualidade rigoroso, segurança do produto e minimização de riscos ao pacientes.
Conformidade com Normas Internacionais
Na Scitec, seguimos rigorosamente as normas ANVISA RDC 301 de 21 de agosto de 2019, RDC 16/2013, ISO 11737-1 e ISO 11737-2. Garantimos que os seus produtos estejam em total conformidade com as regulamentações internacionais.
Independentemente do tipo de produto ou do método de esterilização, temos o teste certo para assegurar que a carga microbiana dele esteja dentro dos parâmetros exigidos.